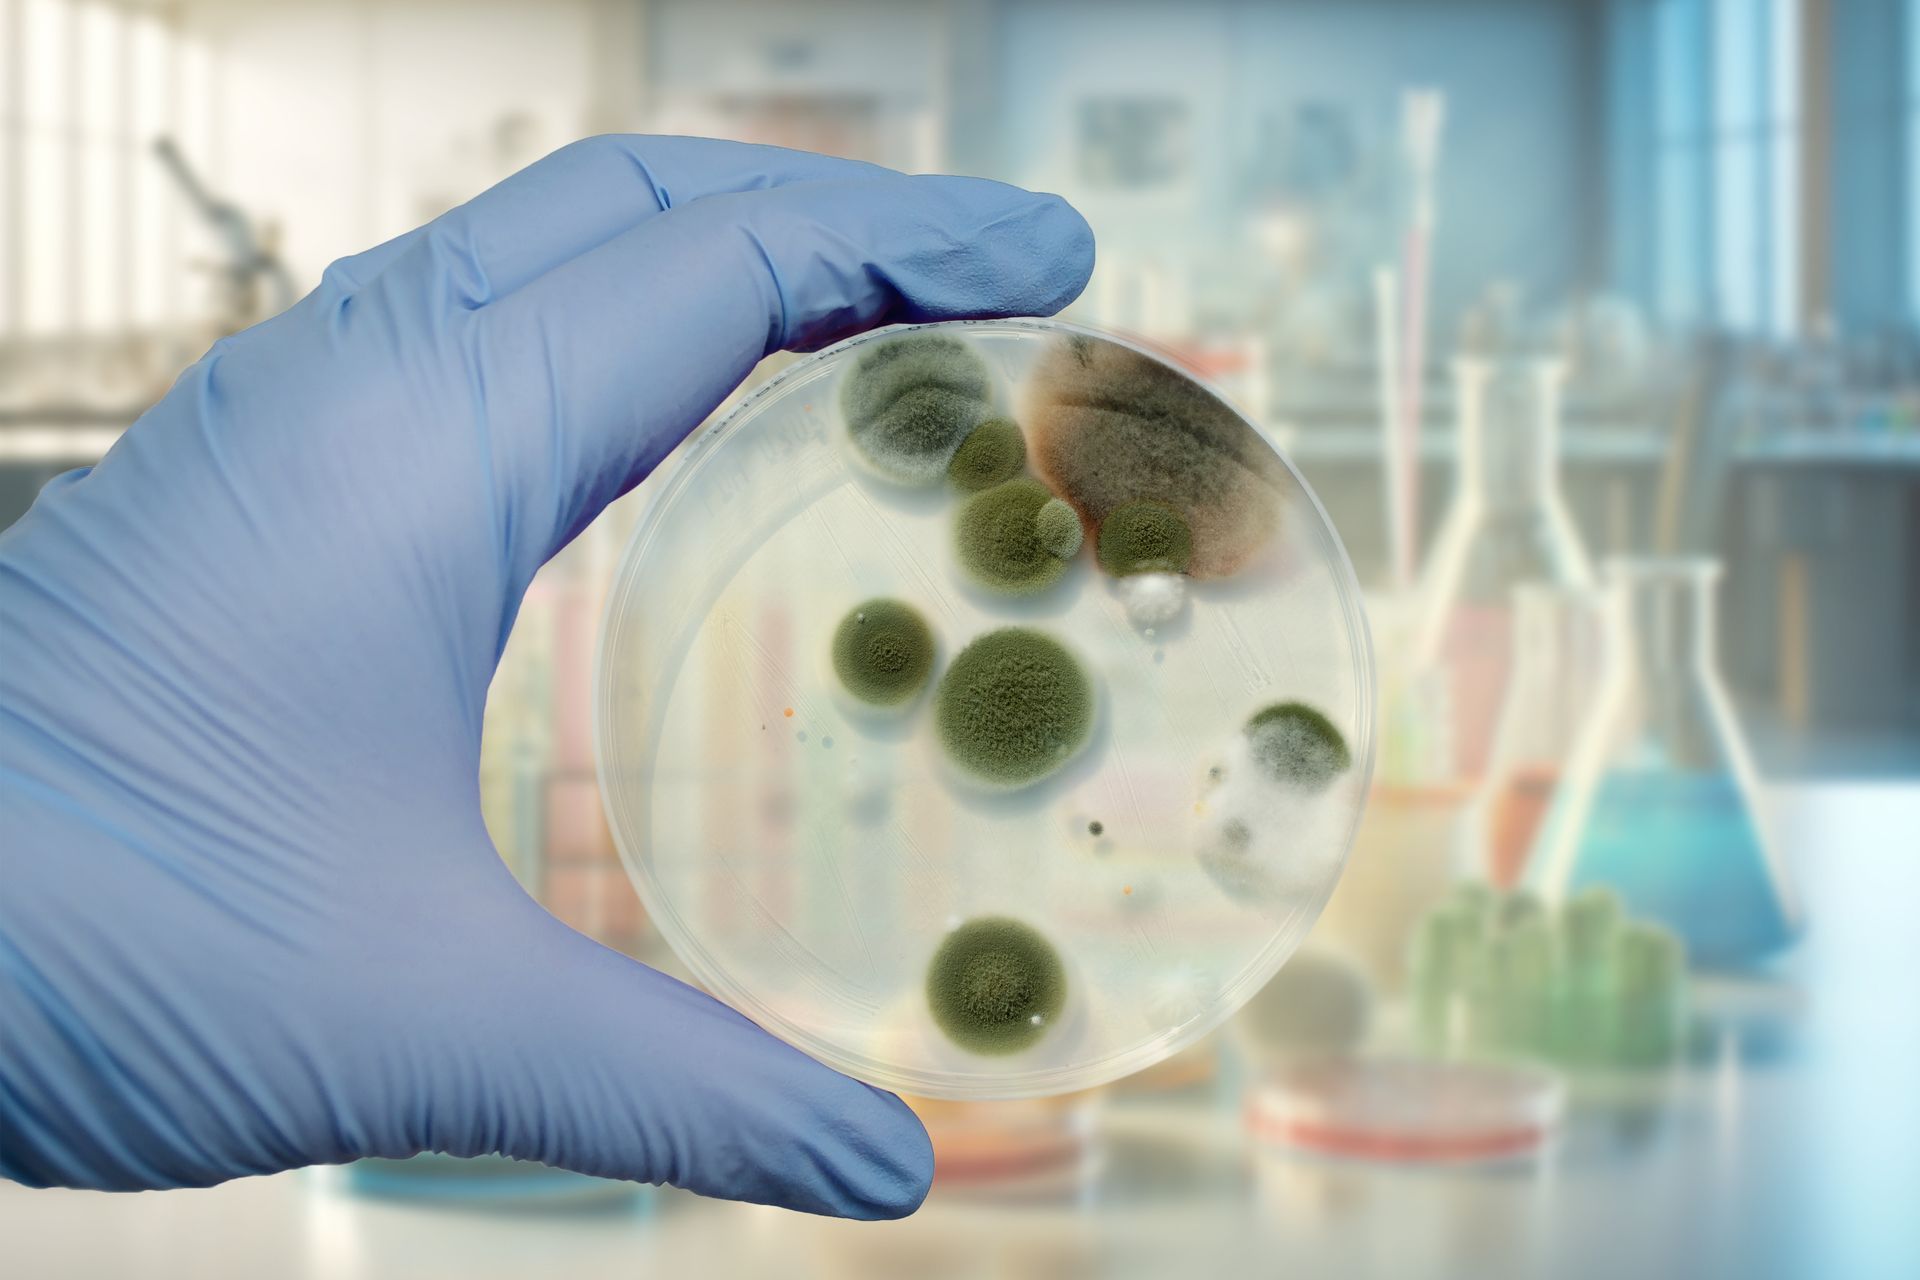
A gloved hand holding a petri dish with green and brown mold colonies in a lab setting.

Indoor Air Quality Testing Services in North Palm Beach, FL
Protecting Your Indoor Environment Since 2007

Comprehensive Environmental Testing for Homes & Commercial Spaces
At RMS Environmental, we specialize in identifying and addressing the invisible threats that impact your health and safety indoors. Our services cover a full range of indoor air quality testing, mold detection, VOC sampling, and allergy assessments, each designed to give you clear insights and peace of mind.
Whether you're experiencing symptoms like fatigue, coughing, or allergy flare-ups—or you simply want to ensure your indoor environment is safe—our expert team provides fast, accurate testing backed by certified laboratory analysis.
Most Popular Services
Our Core Services
Improve your indoor air by targeting the source of airborne pollutants. Our air quality sanitization service helps neutralize mold spores, bacteria, and toxins without harsh chemicals. Ideal for homes, offices, or recently remediated properties, this process refreshes the air you breathe and reduces ongoing contamination risks.
If you’ve noticed musty odors, signs of water damage, or unexplained health symptoms, mold may be the cause. Our testing service identifies hidden or visible mold, mildew, and airborne mold spores using air sampling, surface swabbing, and moisture detection tools.
We inspect:
- Homes and apartments
- Office buildings
- Rental properties
- Post-flood or water-damaged areas
We test for dangerous molds, including Stachybotrys chartarum (black mold), and provide detailed reports to guide remediation if needed.
Indoor allergens are among the top triggers for asthma and chronic respiratory issues. Our allergen testing detects substances like dust mites, pet dander, pollen, mold spores, and VOCs that may be lingering in your home or workplace.
If you or your family experience frequent sneezing, congestion, headaches, or fatigue indoors, a professional indoor allergen assessment can identify the cause.
Additional Testing Capabilities
While mold, allergens, and VOCs are the most common contaminants we test for, we also offer:
- VOC Testing: Volatile Organic Compounds from furniture, flooring, paint, or cleaners
- Bacteria & Mildew Sampling: Especially important after water damage or flooding
- Pre-Purchase & Pre-Rental Inspections: Know what you're buying or renting
- Post-Remediation Verification: Ensure cleanup was successful and the environment is safe
- Real Estate & Legal Reports: Certified documentation for disputes or disclosures
If you're unsure what kind of testing you need, we’re happy to guide you based on your symptoms, property type, or recent history of moisture issues.
Who We Serve
Our services are ideal for:
- Homeowners experiencing musty odors, water damage, or respiratory symptoms
- Landlords & Property Managers ensuring units are safe and compliant
- Tenants needing proof of mold or poor air quality
- Real Estate Professionals needing fast, pre-sale testing or post-inspection backup
- Businesses & Office Managers protecting staff and customers from indoor pollutants
- Remediation Companies seeking third-party testing before and after treatment
We work with residential and commercial clients throughout North Palm Beach and surrounding areas.
What’s Included With Every Service
- On-Site Inspection by trained professionals
- Air, surface, and/or swab sampling using certified methods
- Laboratory analysis through accredited labs
- Detailed written report with findings, photos, and clear explanations
- Guidance on next steps including referrals to trusted remediation partners if needed
- Fast turnaround times with transparent pricing
We’re not a remediation company, so there’s no conflict of interest. Our job is to tell you what’s in your air—honestly, clearly, and without upselling.
Why Choose RMS Environmental?
- Over 15 years of experience in environmental and mold testing
- Certified, lab-based testing with clear, actionable reports
- Locally owned and operated in North Palm Beach, FL
- Prompt scheduling and quick results
- Trusted by homeowners, landlords, and businesses since 2007
We’re committed to helping our clients protect their health and property through proactive indoor air assessments and trustworthy guidance. Every service is handled with care, confidentiality, and a focus on results.
Ready to Get Started?
If you suspect mold, experience allergy symptoms indoors, or simply want peace of mind, contact RMS Environmental today. We’re here to help you identify hidden threats, understand your options, and breathe easier.




